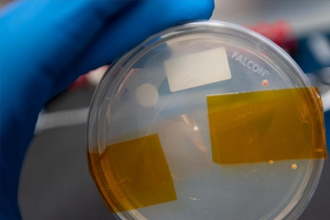

|
发表于 2021-9-25 15:48:14
|
查看: 87 |
回复: 0
太空中弥漫着大量电离辐射,这让宇航员面临着更大的DNA损伤风险。而在人类和其他动物中,受损DNA会诱发癌症等问题。
虽然,细胞能自行修复受损DNA,但由于技术和安全等原因,太空中DNA修复过程整体研究止步不前。
幸运的是,美国JES Tech、MiniPCR Bio、麻省理工学院、怀特黑德生物医学研究所等机构研究人员,开发并展示了一种研究细胞如何在太空中修复受损DNA的新方法。这标志着“基因剪”首次在国际空间站亮出闪亮刀锋。
7月1日,相关论文刊登于《公共科学图书馆—综合》。
“宇航细胞”自我修复可还行?
当人们冲出大气层探索地球以外的空间时,可能面临电离辐射造成的有害DNA损伤。
实际上,在正常的生物过程中,生物体DNA损害时有发生,但环境因素(如紫外线)也可能加重这种问题。幸运的是,细胞有几种不同的自然策略来修复受损的DNA。
其中,双链断裂是DNA损伤的一种类型,其可以通过两种主要的细胞途径进行修复:非同源端连接和同源重组。非同源端连接可以在断裂位点进行额外的添加或删除,同源重组则通常保持DNA序列不变。
先前的研究表明,太空条件可能会影响DNA修复路径的选择。例如,之前有表明,微重力条件可能会影响人体对DNA修复策略的选择,引发了人们对细胞自身修复能力可能不够的担忧。
因此,随着载人航天的不断发展,弄清人体在太空中采用哪种特定的DNA修复策略变得尤为重要。
“我们在地球上使用的许多破坏DNA的技术(比如辐射),在太空中使用都被认为是不安全的。”论文通讯作者之一、MiniPCR Bio的Emily Gleason告诉《中国科学报》。
CRISPR/Cas9基因组编辑技术利用CRISPR酶对人类DNA进行切割,能够人为有效地改变DNA。”该技术在此之前还没有在太空中进行过,但这次我们利用新技术成功地在国际空间站使用了它。这也是第一次在太空中完成整个分子生物学工作流程。”
“剪开”DNA双链
“太空基因”项目的Sarah Stahl-Rommel及其同事于,开发了一种研究酵母细胞DNA修复的新方法,它主要基于CRISPR/Cas9技术,能诱导DNA断裂和评估生物体如何选择针对完全在空间中出现的双链断裂的修复途径。
“这种方法完全可以在太空中进行。”Rommel表示,“这项技术借助‘基因剪’对DNA链进行精确损伤,这样与辐射或其他原因造成的非特异性损伤相比,人们可以更详细地观察到双链断裂后的DNA修复机制。”
研究人员在国际空间站上的酵母细胞中证明了这种新方法的可行性。他们希望借助这项技术在太空中进行广泛的DNA修复研究。他们不仅在极端环境下成功部署了CRISPR/Cas9基因组编辑、聚合酶链反应和纳米孔测序等新技术,而且能够将它们整合到一个功能完整的生物技术工作流程中,适用于DNA修复和微重力条件下其他基本细胞过程研究。
这不仅标志着CRISPR/Cas9基因组编辑首次在太空中成功进行,也是活细胞首次在太空中成功进行转化——整合来自生物体外部的遗传物质。这些里程碑标志着国际空间站上分子生物学工具包的重大扩展。资深作者Sebastian Kraves说,“这些发展让团队对人类探索和居住广阔太空的新探索充满了希望。”
NASA约翰逊太空中心微生物学家Sarah Castro-Wallace说:“我其令人难以置信的复杂性所震撼,我们看到,当一个生物体被转化时,它的基因组被CRISPR/Cas9编辑,出现DNA断裂,然后生长并修复DNA,最后,人们再测序它的DNA,所有这些都是在国际空间站的太空飞行环境中完成的。执行这种包罗万象、端到端调查的能力是空间生物学向前迈出的巨大一步。”
“成为太空六号基因计划的一员是我职业生涯的亮点。我亲眼看到,当学生们的创新想法得到来自学术界、工业界和美国宇航局的支持时,可以取得多大的成就。团队的专业知识也使学生们能够在地球之外进行高质量、复杂的科学研究。”Rommel告诉记者,“我希望这一影响深远的合作能够继续向学生和高级研究人员展示我们实验室在太空中的可能性。”
创造了无数首次的高中生挑战
太空六号基因计划实际上是“太空基因计划”的一部分。
波音公司和miniPCR生物公司合作开展的“太空基因计划”始于2015年,是一项免费的高中生科学竞赛,国际空间站美国国家实验室和新英格兰生物实验室等为该项目提供了支持。
参赛学生可以为国际空间站设计DNA实验。太空一号基因计划是由首个获胜者Anna-Sophia Bogaraev设计的,而太空六号基因计划是由来自明尼苏达州的高中生团队设计的,他们在2018年的竞赛中获胜。
太空一号基因计划标志着聚合酶链反应首次在太空中使用miniPCR热循环扩增DNA,随后不久研究人员开始能使用MinION设备测序DNA。太空三号基因计划结合了这两项成果,进行了在微重力下微生物鉴定完整过程,这是首次在空间站上完成完整样本测序。
在太空中识别微生物可以帮助宇航员实时诊断和治疗疾病,也有助于识别其他星球上以DNA为基础的生命。该研究首先采集微生物样本,进行聚合酶链反应扩增,然后进行测序和鉴定。NASA宇航员 Peggy Whitson在国际空间站进行了这项实验,Wallace团队在休斯顿观察并指导她。
作为常规微生物监测的一部分,培养皿被置于空间站的不同表面。大约一周后,Whitson将培养皿中生长的菌落中的细胞转移到微型试管中,这在太空中是前所未有的。成功收集到这些细胞后,Whitson就可以分离DNA并为测序做准备,进而鉴定未知的生物体——这是太空微生物学的又一个首次。
“在技术方面,太空六号基因计划利用了太空一号和三号基因计划开发的技术,但增加了在太空转化和编辑活细胞的额外步骤。”Gleason说,未来,研究人员将改进这种新方法,以更好地模拟电离辐射造成的复杂DNA损伤。这项技术还可以作为研究与长期空间接触和探索有关的许多其他分子生物学主题的基础。
相关论文信息:https://doi.org/10.1371/journal.pone.0253403
国际空间站首次成功使用新技术研究酵母DNA修复
本文转载自: 中国科学报
2021-07-02
作者:唐凤 |
|